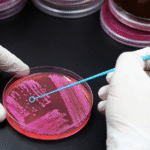
Urban Microbiome and Human Immunity: How City Life Shapes Your Gut and Skin Health

Introduction:
Health and the environment are inseparable. Every breath, sip of water, and meal depends on the ecosystems that sustain life. The concept of eco-health—or health ecology—looks beyond hospitals and medicines to study how human well-being is tied to the planet’s health. In a changing climate, this link has never been more urgent.

What Is Eco-Health or Health Ecology?
Eco-health is the study of how ecological systems influence human health. It combines ecology, public health, and social sciences to understand disease emergence, nutrition, and resilience in relation to environmental balance.
Key principles:
- Human health depends on clean air, water, soil, and biodiversity.
- Ecosystem disruptions (deforestation, pollution, urban sprawl) lead to new or intensified diseases.
- Solutions require collaboration between health, agriculture, and environmental sectors.
How Ecosystem Health Affects Human Health
- Infectious diseases: Habitat loss brings humans closer to wildlife, increasing the spread of zoonotic infections such as Nipah or COVID-19.
- Air and water quality: Poor air and contaminated water drive chronic respiratory and gastrointestinal diseases.
- Food security: Soil degradation and loss of pollinators reduce nutrient quality and food supply.
- Mental well-being: Exposure to green spaces lowers stress and improves cognitive health.
Eco-Health in the Indian Context
India faces unique eco-health pressures due to dense populations and rapid development.
- Urban pollution: Major cities like Delhi and Mumbai see severe air-quality-related illnesses.
- Deforestation and vector-borne disease: Clearing of forests in states like Assam and Kerala correlates with higher malaria and dengue rates.
- Water scarcity: Overextraction of groundwater and poor sanitation trigger outbreaks of water-borne diseases.
- Traditional knowledge: Indigenous communities often hold eco-health practices—crop rotation, herbal medicine, biodiversity protection—that modern systems can learn from.
Challenges and the Way Forward
- Fragmented policies: Environmental and health ministries often operate separately.
- Lack of data linking environmental factors with health outcomes.
- Weak public awareness about ecosystem services.
Future outlook:
- Integrated “One Health” frameworks that connect veterinary, environmental, and human medicine.
- Urban greening and pollution-control programs as public health measures.
- Eco-health education in medical and environmental curricula.
Conclusion:
Human and environmental health are one system. Treating them separately leads to incomplete solutions. By restoring ecosystems and respecting ecological limits, societies can prevent disease, improve well-being, and build resilience against future crises. The health of the planet is, ultimately, the health of humanity.